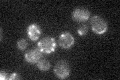
YPR024W

View description
Catalytic subunit of the mitochondrial inner membrane i-AAA protease complex, which is responsible for degradation of unfolded or misfolded mitochondrial gene products; mutation causes an elevated rate of mitochondrial turnover
Localization:
Intensity:
Fold change:
Significance:
-
C’ GFP library in SD

mitochondria28.92 -
N' NOP1pr-GFP in SD

mitochondria37.4399 -
N' TEF2pr-mCherry in SD

cell periphery,vacuole0 -
N' NATIVEpr-GFP in SD

missing0 -
N' TEF2pr-VC and Cyto-VN in SD

#N/A0 -
C’ GFP library in SD+DTT

mitochondria25.160.86No -
C’ GFP library in SD+H2O2

mitochondria27.410.94No -
C’ GFP library in Starvation Media
mitochondria21.890.75No -
C’ GFP library on the background of Pup2-DaMP

mitochondria -
C’ GFP library on the background of CCT mutant

mitochondria21.03470.727114No
